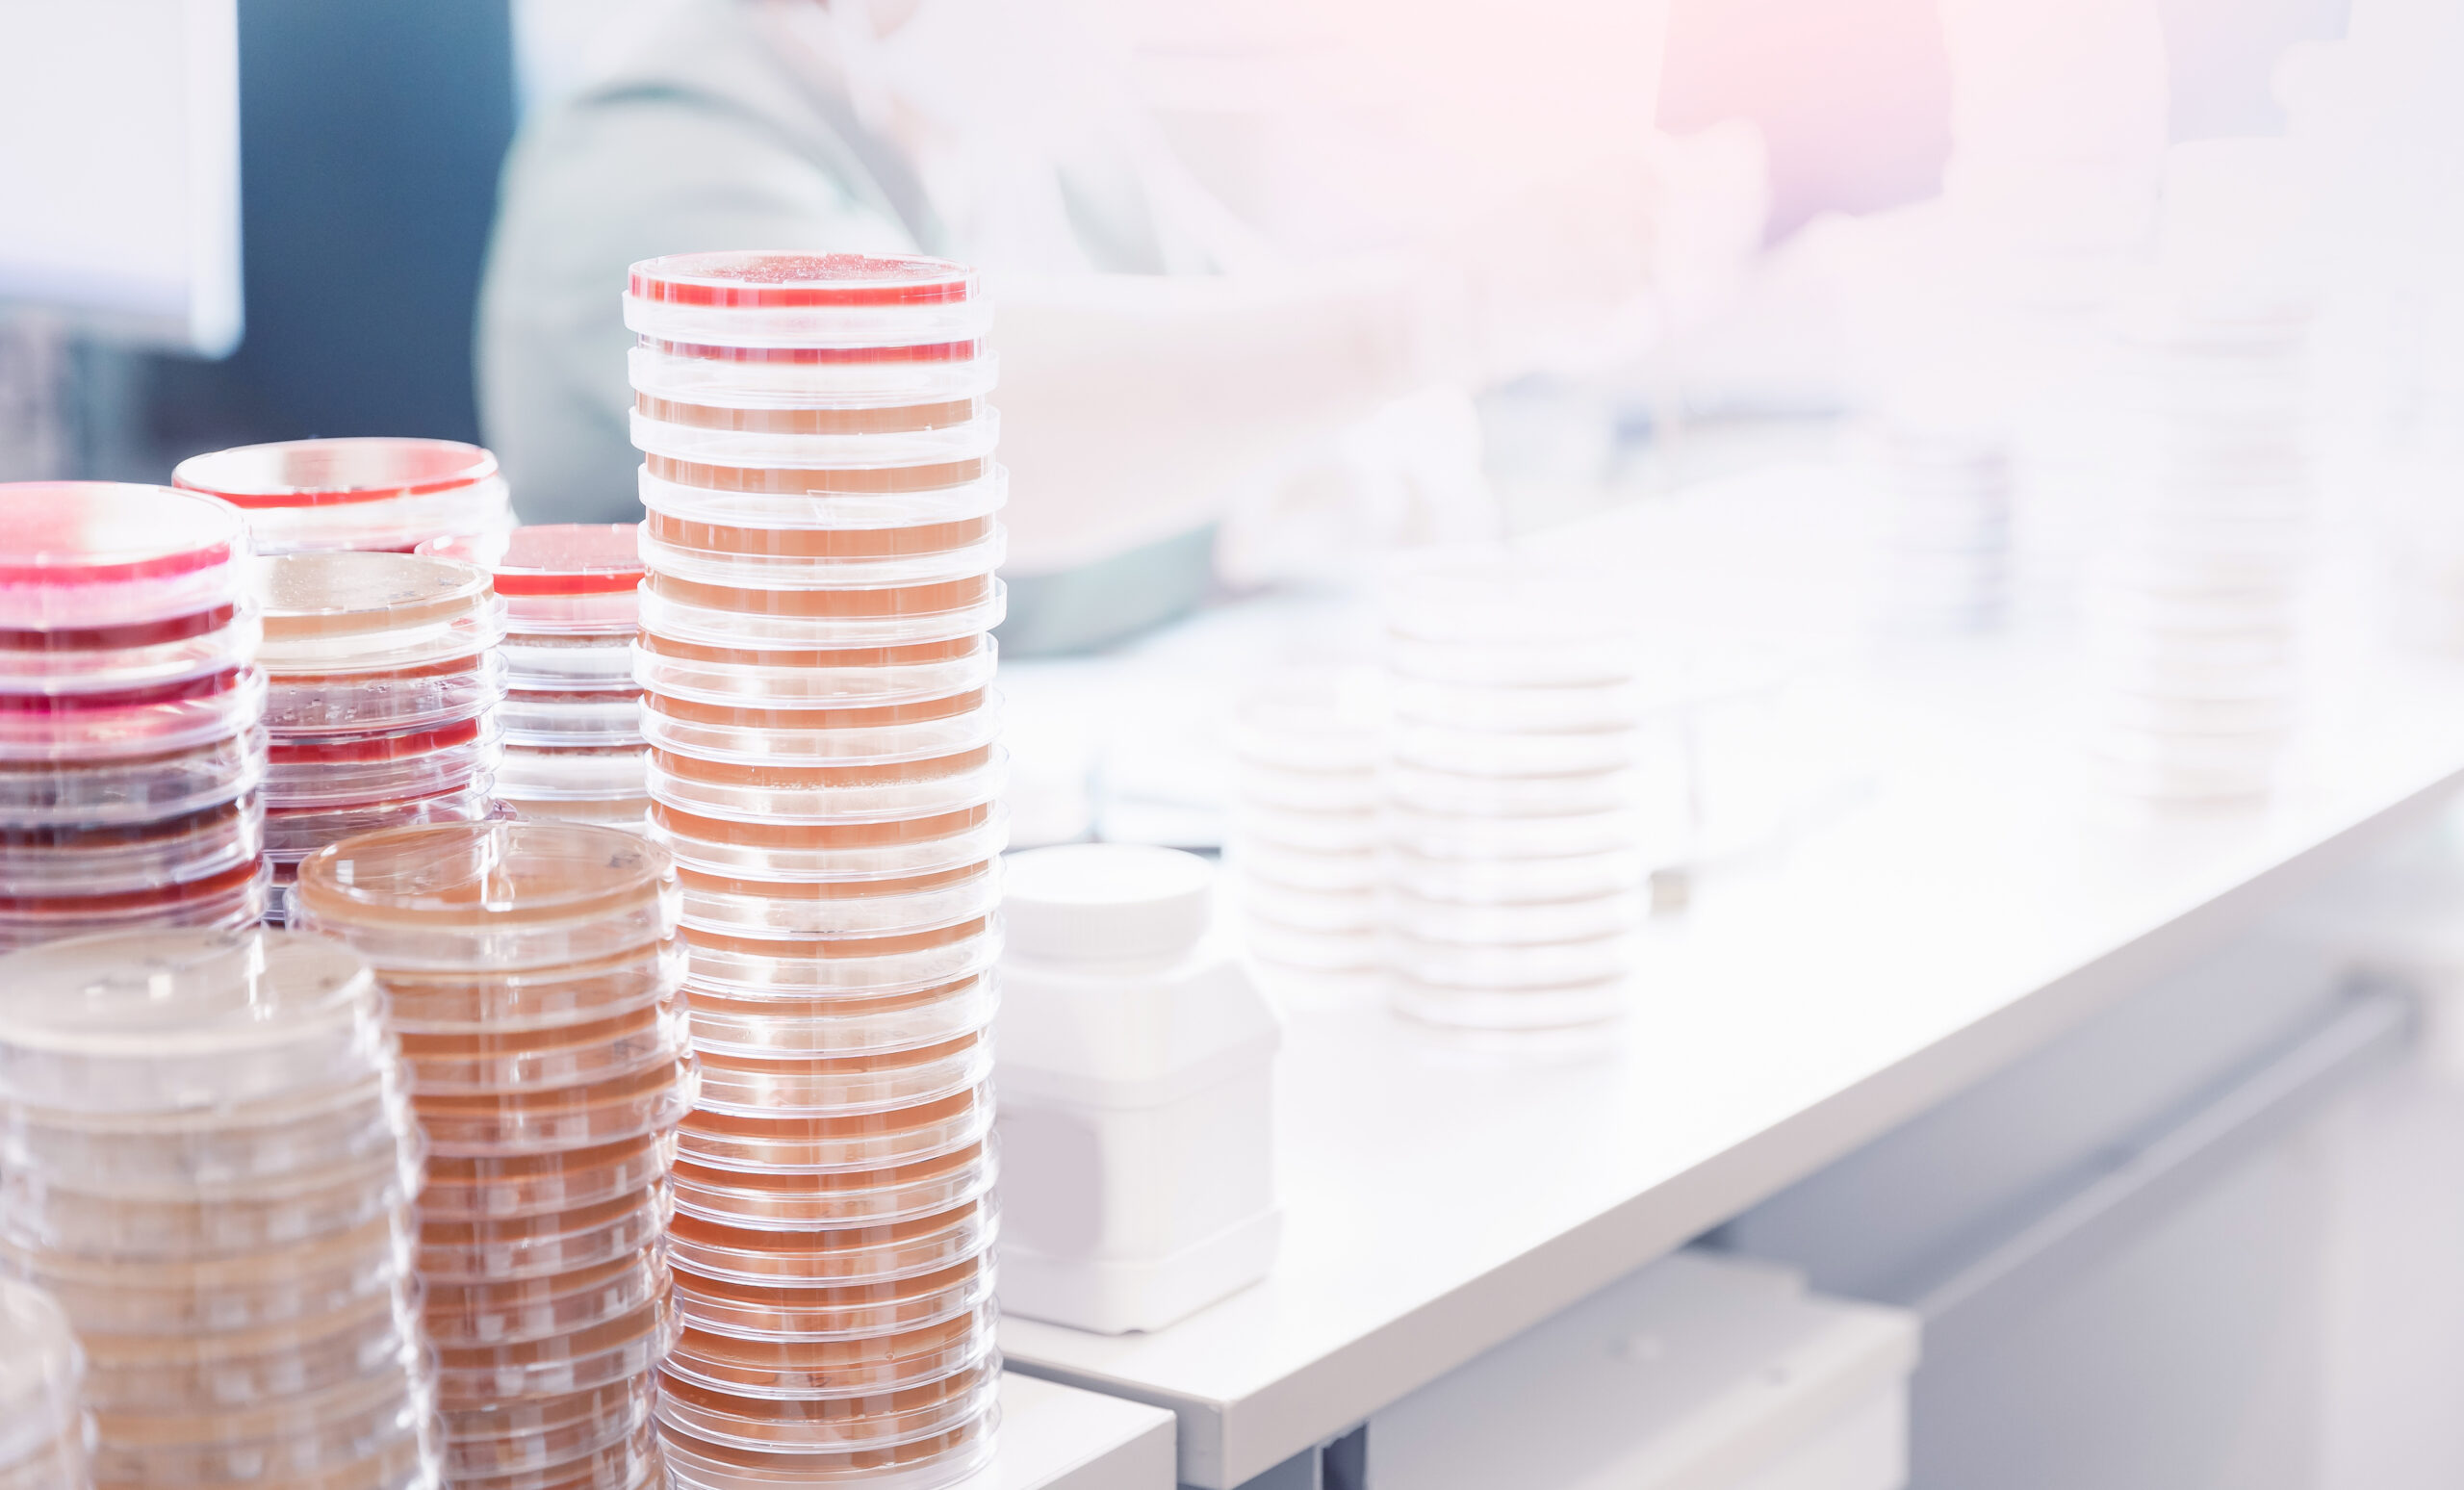

Bei jeder sechsten bakteriellen Infektion weltweit liegen Antibiotikaresistenzen vor. Das macht die Therapie schwieriger und teurer.
-
Fünf Tipps für eine kompetente Beratung
Wer hat ein erhöhtes Risiko für einen Vitamin-B12-Mangel? Wie hoch sollte Vitamin B12 dosiert und in welcher Form eingenommen werden? Erfahren Sie, worauf bei der Beratung zu achten ist.
-
Metabolischer BMI schlägt BMI
Übergewicht wird als wichtiger Risikofaktor für Erkrankungen angesehen. Definiert wird es meist über den BMI, der jedoch nicht in Korrelation zum Stoffwechsel steht. Forschende aus Leipzig wurden nun für ein neues Konzept ausgezeichnet.
-
Wenn Forschung die Offizin trifft
Netzwerke aus Forschungsapotheken in verschiedenen Ländern haben eindrucksvoll gezeigt, dass öffentliche Apotheken nicht nur einen wichtigen Beitrag zur Versorgung sondern eben auch zur Versorgungsforschung leisten können. Um auch in Deutschland eine strukturierte Forschungsinfrastruktur mit öffentlichen Apotheken zu etablieren, wurde ein Einstiegsprogramm für das Netzwerk für exzellente Forschung in Apotheken (Nefa) entwickelt.
-
Warken: „Mit Digitalisierung sparen, nicht an ihr“
Überfüllte Halle, warmer Applaus – bei der Eröffnung der diesjährigen DMEA traf Gesundheitsministerin Nina Warken auf viel Sympathie. Kein Wunder, versprach sie doch, bei der Digitalisierung des Gesundheitswesens „Gas zu geben“.
-
Neue Hinweise zu Captopril, Cefixim und Codein-Kombinationen
Captopril kann auch nach Jahren noch Angioödeme auslösen, Cefixim eine Enzephalopathie. Codein-haltige Schmerzmittel-Kombinationen bekommen gleich mehrere neue Warnungen. Neues gibt es auch bei Gabapentin. Was ändert sich in den Fach- und Gebrauchsinformationen?
-
Schönes neues Arbeiten: Chancen der Cloud in der Apotheke
Digitale Prozesse verändern die organisatorischen Strukturen in der Apotheke grundlegend. Welche Rolle spielen dabei cloudbasierte Systeme? Erfahren Sie mehr und sichern sich 100 DAP-Punkte.